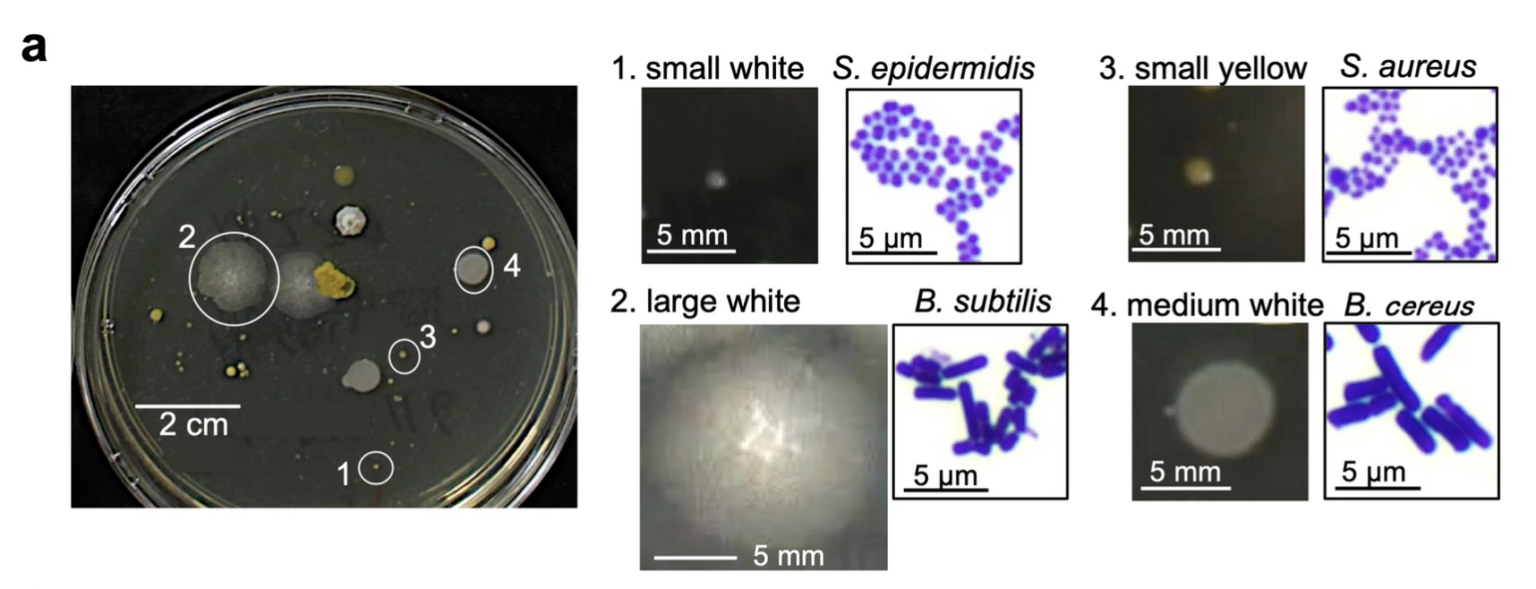

{jcomments off}Kritici odborníci silne pochybujú o užitočnosti masiek v každodennom živote. Zároveň sú zvyšky materiálu všetko, len nie neškodné: nielenže môžu mať opačný účinok v boji proti Covidu a dokonca zvýšiť úmrtnosť - tiež oslabujú imunitný systém. Okrem toho masky vytvárajú dokonalé prostredie pre plesne a baktérie. Nová štúdia z Japonska identifikovala, čo rastie v úlomkoch: Výsledkom je dlhý zoznam škodlivých mikróbov...
Štúdia „Bakteriálna a plesňová izolácia z tvárových masiek v rámci pandémie COVID-19“ sa objavila 18. júla vo „Vedeckých správach“. Štúdie sa zúčastnilo 109 účastníkov vo veku 21 až 22 rokov, ktorých sa pýtali na typ a trvanie použitej masky a ich životný štýl. Baktérie a plesne boli zozbierané z troch typov masiek – gázovej, polyuretánovej a netkanej – ktoré sa nosili od septembra do októbra 2020.
Zatiaľ čo vnútorná strana masky smerujúca k tvári mala tendenciu zhromažďovať viac baktérií, vonkajšia strana obsahovala viac húb. Len pri trojvrstvových fleecových maskách bola na vonkajšej strane nižšia miera osídlenia hubami. Dĺžka nosenia masky vo všeobecnosti nezvýšila počet baktérií, ale zvýšila počet húb, ktoré sa usadili v tkanive. Autori zistili, že huby a ich spóry sú odolné voči vysychaniu masiek: aj keď maska už nie je vlhká, prežijú tam.
Životný štýl nositeľov masiek nemal na zistenia žiadny vplyv: pravidelné kloktanie neznižovalo počet mikróbov, ani nerozhodovalo, či ľudia na cestovanie využívajú verejnú dopravu, vlastné auto alebo bicykel.
P Zoznam izolovaných mikróbov nájdených v maskách je dlhý. Existuje niekoľko patogénov, ktoré spôsobujú ochorenie. Zvyšok tvoria väčšinou takzvané oportúnne patogény, ktoré u zdravých ľudí spôsobujú ochorenie len zriedka, ale u ľudí s oslabeným imunitným systémom áno. Opatrenia prijaté počas takzvanej pandémie sú, žiaľ, už dobre známe, že spôsobujú presne toto. Opatrenia zničili imunitný systém !!
Nižšie nájdete zoznam identifikovaných baktérií a húb. Patogénne patogény sú označené +. Ostatné mikróby sú tiež nebezpečné, najmä pre ľudí s oslabeným imunitným systémom.
Baktérie:
Screenshot / Quelle
Vonkajšia strana masky:
- Bacillus cereus (+)
- Bacillus firmus
- Bacillus flexus
- Bacillus simplex
- Curtobacterium flaccumfaciens
- Curtobacterium luteum
- Erwinia aphidicola
- Massilia oculi (+)
- Paenibacillus illinoisensis
- Pseudarthrobacter defluvii
- Pseudomonas asplenii
- Pseudomonas luteola
- Sphingobacterium detergens
- Sporosarcina koreensis
- Stenotrophomonas rhizophila
Vnútro masky:
- Deinococcus proteolyticus
- Enterobacter asburiae
- Pantoea ananatis
Obe strany:
- Bacillus subtilis
- Staphylococcus aureus (+)
- Staphylococcus epidermidis
- Staphylococcus saprophyticus (+)
Huby:

Screenshot / Quelle
- Cladosporium
- Fonsecaea (+)
- Mucor (+)
- Trichophyton (+)
- Rhodotorula
- Penicillium
- Microsporum (+)
- Alternaria
- Malassezia
- Aspergillus (+)
- Fusarium (+)
- Geotrichum
- Pleurostomophora
Petícia za vyhlásenie referenda
S prosbou. Financujeme sa výlučne prostredníctvom vašich darov. Veľká vďaka
Všetky práva vyhradené © OZ Dôstojnosť Slovenska.